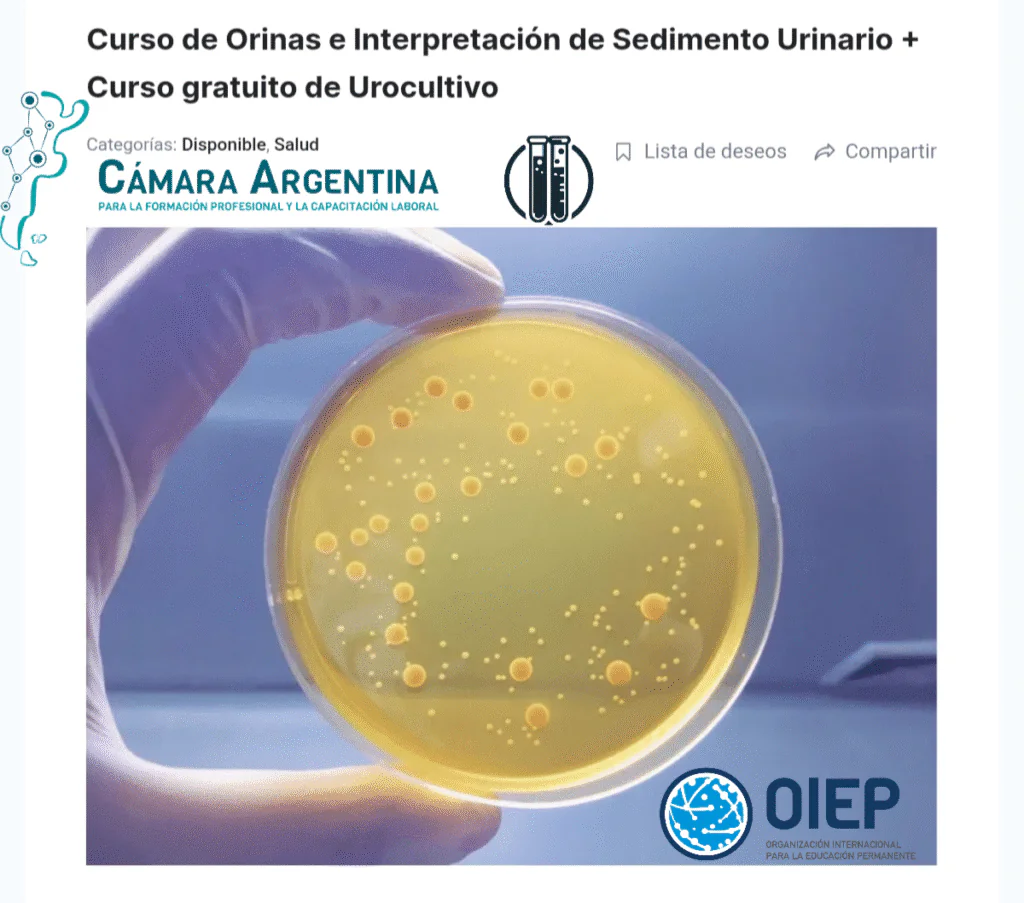
Sedimento Urinario + Urocultivo

Curso de Sedimento Urinario + Urocultivo
Curso de Orinas e Interpretación de Sedimento Urinario Domina una de las herramientas diagnósticas más importantes en el laboratorio clínico: el análisis de orina. En este curso aprenderás desde los fundamentos del uroanálisis hasta la correcta identificación e interpretación del sedimento urinario, incluyendo células, cristales, cilindros y elementos patológicos relevantes. ¿A quién va dirigido?A profesionales […]
Curso de Sedimento Urinario + Urocultivo Leer más »